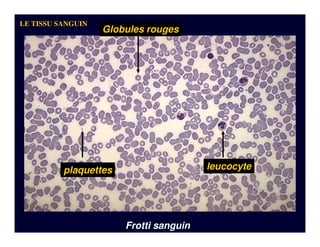
Letissusanguin

Intégrer la présentation
Télécharger en tant que PDF, PPTX













































Ce document présente le tissu sanguin, sa composition, ses fonctions et ses éléments figurés, notamment les globules rouges, les globules blancs et les plaquettes. Il aborde également les anomalies sanguines telles que l'anémie et la polyglobulie, ainsi que les différents types de leucocytes et leur rôle dans le système immunitaire. Le document détaille la fonction des plaquettes dans l'hémostase et les mécanismes de coagulation.